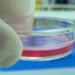
Οι εξαιρέσεις ασθενών από την επιβάρυνση 1 και 3 ευρώ για διαγνωστικές εξετάσεις

Η ομάδα «Χοιροκίνητοι», υπό την αιγίδα του Δήμου Ηρακλείου, συνδιοργανώνει με την Περιφέρεια Κρήτης το 13ο Παιδικό Κυνήγι Κρυμμένου Θησαυρού. Το παιχνίδι θα πραγματοποιηθεί την Κυριακή 26 Μαΐου 2024, στο πάρκο Γεωργιάδη, από τις 11:00 έως τις 14:00, και απευθύνεται σε παιδιά της Ε’ και ΣΤ’ δημοτικού.
Το Παιδικό Κυνήγι Κρυμμένου Θησαυρού είναι μια μοναδική ευκαιρία για τα παιδιά να αναπτύξουν την ομαδικότητα, τη συνεργασία και την παρατηρητικότητά τους μέσα από διασκεδαστικές και εκπαιδευτικές δραστηριότητες. Κατά τη διάρκεια του παιχνιδιού, τα παιδιά θα κληθούν να λύσουν γρίφους και να ακολουθήσουν ενδείξεις για να ανακαλύψουν τον κρυμμένο θησαυρό, βιώνοντας μια αξέχαστη εμπειρία.
Οι εγγραφές μπορούν να γίνουν καθημερινά, από Δευτέρα έως Παρασκευή, από τις 18:00 έως τις 21:00, στο περίπτερο της διοργανώτριας ομάδας στη Λεωφόρο Δικαιοσύνης. Συστήνεται στους ενδιαφερόμενους να εγγραφούν έγκαιρα, καθώς οι θέσεις είναι περιορισμένες.
Για περισσότερες πληροφορίες, στις σελίδες της διοργανώτριας ομάδας Χοιροκίνητοι στο Facebook και το Instagram.
Το άρθρο “Την Κυριακή το 13ο Παιδικό Κυνήγι Κρυμμένου Θησαυρού“, δημοσιεύθηκε για πρώτη φορά στο CRETA24.